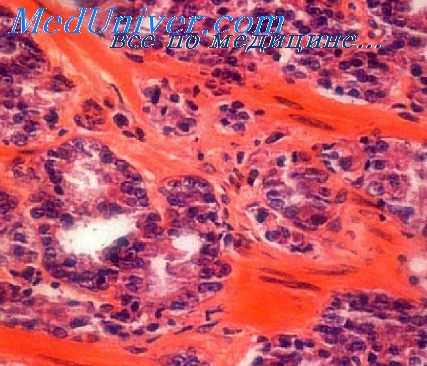
аденома простаты

Кто застрахован от аденомы простаты? Проявления и выявление аденомы предстательной железы
Добавил пользователь Дмитрий К. Обновлено: 08.11.2025
Кто застрахован от аденомы простаты? Проявления и выявление аденомы предстательной железы
Только евнух или кастрат, к сожалению застрахованы от аденомы простаты. Все остальные мужчины, имеющие детородные органы и соответствующий уровень тестостерона, находятся в группе риска.
Проблематика аденомы простаты
Аденома или доброкачественная гиперплазия - это разрастание ткани простаты вокруг мочевыводящего канала. Сама по себе аденома простаты безвредна, никаких веществ в кровь она не выделяет, опасность представляет именно сдавление мочеточника. Степень и скорость разрастания тканей находятся в линейной зависимости от уровня основного мужского гормона тестостерона - чем он выше, тем риск больше. Самые активные "мачо" или альфасамцы рискуют больше других.
Распространенность аденомы простаты
Доброкачественная гиперплазия простаты - одно из самых распространённых урологических заболеваний мужчин. Вероятность её развития повышается с возрастом. До 40 лет предстательная железа в большинстве случаев функционирует нормально, этот возраст считается возможным началом изменений в тканях. С этого возраста желательно посещать уролога или андролога с профилактической целью хотя бы раз в год.
По статистике у половины мужчин старше 50 лет уже есть признаки заболевания. Среди 70-летних число заболевших приближается к 70-75%, и дальше с возрастом только растёт.
Среди городских жителей заболевание встречается несколько чаще, чем у сельских. Низкий уровень заболеваемости отмечается в странах Азии и Африки, исследователи связывают этот факт с особенностями питания, в частности с широким употреблением растительных масел. Предположение верное - многие эффективные препараты, сдерживающие развитие гиперплазии, содержат полиненасыщенные жирные кислоты в составе вытяжки из масел растений.
Особое внимание обращается на семейную историю - наличие заболевания у близких родственников считается фактором риска.

История изучения аденомы простаты
Аденома простаты известна столько, сколько живёт человечество. Описывал это страдание - правда, без названия - ещё Авиценна. Он называл заболевание "мочеиспусканием по каплям" и советовал больным употреблять в пищу инжир в оливковом масле.
Развитие медицины постепенно привело к улучшению оказываемой помощи больным и увеличению длительности их жизни. Так, если ещё в 18 -начале 19 века пациенты иногда погибали от мочевой интоксикации, то в последующем в мочевой пузырь стали вводить катетер для прямого оттока. Этот метод до сих пор ещё используют у очень пожилых или ослабленных мужчин.
Дальнейшее изучение строение и функции органа привели к тому, что стало возможным хирургическое удаление разросшейся железы. Вначале простату удаляли доступом через мочевой пузырь вслепую, ориентируясь на ощущения рук хирурга. Эта операция называется "вылущивание", очень травматична, иногда возникают осложнения, связанные с попаданием крови из обширной раневой поверхности в мочевой пузырь, но она радикально избавляет человека от страданий. Если послеоперационный период закончился благополучно, человек навсегда забывает о болезни.
Впоследствии оперативное вмешательство было модифицировано, врачи научились удалять простату через уретру. Такой доступ уменьшил травматичность и количество осложнений. Сегодня эта методика повсеместно используется.
Когда была выяснена роль тестостерона, появились лекарственные препараты, удерживающие уровень этого гормона на нужном уровне. Многим больным приём таких препаратов успешно заменяет оперативное лечение - железа уменьшается в размере и не мешает больше оттоку мочи.
Развитие новых технологий привело к тому, что сейчас успешно используется методика испарения простаты зелёным лазером. Это вмешательство проводится уже под визуальным контролем - врач видит всё, что он делает, на мониторе. Инструмент вводится через мочеточник, разросшаяся ткань испаряется, остатки вымываются наружу. Такой способ применяется недавно, пациент может уйти домой уже на следующий день, осложнений практически нет.

Ключевые признаки аденомы простаты
Основным признаком разрастания простаты является изменение струи мочи. Старые врачи говорили, что "струя не должна попадать на носок сапога".
Очень долго аденома никак себя не проявляет - не болит и не беспокоит. Насторожиться нужно тогда, когда мочеиспускание сопровождается натуживанием - иначе моча не вытекает. Могут появиться учащённые позывы, особенно ночью, запаздывание начала мочеиспускания, дискомфорт. В это время мочевой пузырь ещё полностью освобождается, а лечиться можно консервативно.
Признаки, при которых нужно обращаться к врачу:
- Вялая струя мочи
- Мочеиспускание прерывистое и затруднённое
- Чувство неполного опорожнения пузыря.
Если ничего не делать, в пузыре начинает оставаться моча, а все отделы мочеиспускательного канала растягиваются и теряют тонус. Иногда может возникать острая задержка мочи, беспокоит чувство неполного опорожнения.
Нелеченная аденома приводит к тому, что мочи в пузыре остаётся всё больше, тонус мускулатуры утрачивается, моча выделяется каплями при переполненном пузыре, и присоединяется инфекция. В наше время терминальная стадия почти не встречается, пациенты получают адекватное лечение раньше.
Инструментальная диагностика аденомы предстательной железы
Для диагностики стадии заболевания используются:
- пальцевое исследование через прямую кишку
- определение уровня антигена к простате в крови
- УЗИ мочевого пузыря с определением уровня остаточной мочи
- Общеклинические анализы крови и мочи
- Рентгеновское и радиоизотопное исследование функции почек.
Инструментальное исследование через уретру - биопсия, внутренний осмотр мочевого пузыря - применяется редко и только по строгим показаниям, чтобы не нарушить хрупкое равновесие больных органов.
Совокупность характерных признаков позволяет точно установить степень страдания и подобрать наиболее подходящий способ лечения.
- Вернуться в оглавление раздела "Профилактика заболеваний"
Информация на сайте подлежит консультации лечащим врачом и не заменяет очной консультации с ним.
См. подробнее в пользовательском соглашении.
Клиника аденомы предстательной железы. Признаки аденомы простаты
Основным признаком аденомы предстательной железы является нарушение акта мочеиспускания. Учащенное мочеиспускание (особенно в ночное время) часто является первым и долгое время единственным признаком заболевания. В начальный период больные могут и не замечать разницы в учащении мочеиспускания в дневное и ночное время.
Только молодые мужчины сразу же замечают ослабле ние струи мочи и удлинение акта мочеиспускания.
Аденома предстательной железы является относительно частым заболеванием у мужчин старше 50 лет. Однако описано большое количество наблюдений аденомы у лиц в возрасте 40—49 лет (Pavpne, l965, и др.).
Как показали результаты наших двадцатилетних наблюдений, среди различных заболеваний почек и мочевыводящих путей аденома предстательной железы у мужчин пожилого и старческого возраста составляет 74 %.
Одним из основных признаков аденомы предстательной железы, характерным для всех периодов развития, является расстройство акта мочеиспускания (повелительные позывы, учащение и затруднение). Степень этого расстройства постепенно нарастает. Однако образование аденомы не всегда сопровождается расстройством мочеиспускания.
Симптомы затрудненного мочеиспускания, по данным различных авторов, отмечаются у 35—50 % больных, по нашим данным,— у 64 %. Это объясняют тем, что степень увеличения железы при развитии аденомы не всегда соответствует клиническим признакам.
В распознавании аденомы предстательной железы огромное значение имеют данные анамнеза. У 22 % наблюдаемых нами больных заболевание протекало латентно, сопровождаясь незначительными местными расстройствами.
К моменту обращения к врачу у них были явления недостаточности эвакуаторной функции мочевого пузыря и нарушения функции почек. У 4% больных преобладали жалобы на расстройство органов пищеварения, общую слабость, похудение, сухость во рту.
Деление клинического течения аденомы на три стадии по количеству остаточной мочи, по нашему мнению, является условным, так как в ряде случаев уже в первую стадию наблюдаются выраженные изменения со стороны органов мочевой системы.
Для клинического течения аденомы предстательной железы характерен ряд осложнений. В первую и вторую стадии заболевания одним из частых осложнений (на фоне даже умеренно выраженной дизурии) является острая полная задержка мочи. Нередко внезапная задержка мочи является первым симптомом аденомы предстательной железы. По нашим данным, это осложнение встречается у 38,2 % больных.
Острая задержка может продолжаться сутки и больше. Мы наблюдали больных, поступивших в клинику через 3—5 сут после начала острой задержки мочи. У некоторых больных после катетеризации мочеиспускание может восстановиться, но в дальнейшем острая задержка мочи повторяется. Если моча не выводится, может произойти разрыв переполненного мочевого пузыря.
Нередким осложнением аденомы предстательной железы является гематурия. У 8 % наблюдаемых нами больных гематурия была самостоятельным симптомом заболевания. Причиной ее является венозный застой в органах малого таза, которому способствует острая или хроническая задержка мочи.
Иногда кровотечение бывает настолько интенсивным, что возникает необходимость в экстренном оперативном вмешательстве. Причину гематурии нельзя объяснять только наличием аденомы. Необходимо провести тщательное урологическое обследование, чтобы избежать диагностической ошибки.
Мы наблюдали больных, которых без полного урологического обследования взяли на операционный стол для аденомэктомии. Во время операции у одного больного был установлен рак мочевого пузыря, у второго — двусторонние камни почек. Третий больной после аденомэктомии погиб от недостаточности почек, а при аутопсии был обнаружен гипернефроидный рак правой почки.
Рецидив аденомы предстательной железы. Гормональный фон при аденоме простаты
Результаты наших наблюдений и данные литературы позволяют прийти к заключению, что истинный рецидив аденомы предстательной железы есть, по-видимому, следствие роста субуретральных (препростатических) железок — остатков заднего отдела мочеиспускательного канала, неудаленных при операции. Обращает на себя внимание факт сочетания опухолей в других органах и системах и предстательной железе.
Сочетания аденомы предстательной железы с опухолями мочеполовой системы мы наблюдали у 54 больных в возрасте от 49 до 83 лет. Аденома предстательной железы сочеталась с папилломой мочевого пузыря у 7 больных, с плоскоклеточным раком мочевого пузыря — у 5, с сосочковым раком мочевого пузыря — у 6, с гипернефроидным раком правой почки — у 10, левой — у 7, с остроконечными кондиломами полового члена—у 6, с лейкоплакией — у 4 и раком полового члена — у 9 больных.
И. Викторов и соавторы (1978) из 890 больных, оперированных по поводу аденомы предстательной железы, у 27 (3,03%) при гистологическом исследовании выявили рак. У 19 из них он сочетался с аденомой. Патоморфологические исследования позволили прийти к выводу, что рак не был распознан до операции из-за малых размеров опухоли и ее центрального расположения.
Типичное злокачественное перерождение аденомы предстательной железы мы наблюдали в 11,7% случаев и пришли к заключению, что на основании исследования одного кусочка, взятого из какого-либо отдела железы, не всегда удается определить истинное морфологическое состояние удаленного новообразования. Одна половина железы может быть совершенно интактна, а во второй могут быть очаги метаплазии покровного эпителия и многослойный плоский эпителий с последующим переходом в истинный рак. Таким образом, метаплазия в данном случае является как бы переходным моментом от доброкачественной аденомы к развитию участков истинного рака.
Итак, гистологическая структура, способность давать рецидивы после аденомэктомии, способность к. злокачественной трансформации, наличие типичных фибро-, фибро-миоматозных образований в разросшейся железистой ткани и сочетание с другими доброкачественными и злокачественными опухолями позволяют аденому предстательной железы рассматривать как типичную бластому.

Данные о биосинтезе андрогенов у больных с гиперпластическими процессами предстательной железы весьма ограничены, так как для получения их необходим сбор оттекающей от яичек крови.
Moon и Flocks (1970), Farnworth (1971), Harder и соавторы (1976), Hammond и соавторы (1978), Ortega и соавторы (1979) наблюдали уменьшение уровня тестостерона у мужчин с аденомой предстательной железы. Это подтверждает представление о патогенетическом значении, дефицита андрогенов в развитии доброкачественной опухоли предстательной железы.
Однако другие авторы не обнаружили изменений в концентрации плазменного тестостерона, ДГТ, андростендиона и андростендиола в периферической крови больных, с аденомой предстательной железы (Becker и соавт., 1973; Bayard и соавт., 1974; Griffits, 1974; Skoldefors и соавт., 1978; Bartsch и соавт., 1979).
Некоторые авторы отметили даже повышение уровнд тестостерона (Zgliczynski и- Baranowska, 1979; Baranowska и Zgliczynski, 1979). По данным Orestano и Altwein (1976), из 23 обследованных пациентов у 15 содержание плазменного тестостерона было в норме, у 3 — понижено, у 5 — повышено. Таким образом, сделать окончательное заключение об изменении уровня циркулирующего тестостерона у больных аденомой невозможно. При анализе причин выявленных расхождений учитывали различные факторы, в частности возраст больных.
У мужчин 60—70 лет (Vermeulen и De Sy, 1976; Hammond и соавт., 1977) различий в содержании тестостерона по сравнению с контрольной группой не выявлено, однако у мужчин от 70 до 80 лет оно было повышено. Аналогичную зависимость для андростандиола подметили Bartsh и соавторы (1979).
Важно проанализировать соотношения различных андрогенов у больных аденомой предстательной железы, поскольку биологическое действие их на этот орган неоднозначно. Horton и соавторы (1975), Hammond и соавторы (1977) сообщили, что у указанного контингента больных преобладает ДГТ. В плазме больных аденомой 60—90 лет содержание тестостерона было пониженным, а уровень ДГТ повышенным по сравнению с их уровнем в крови мужчин 20—29 лет.
По-видимому, увеличение уровня ДГТ в крови характерно для этого заболевания и не зависит от возраста больного, поскольку в наблюдениях Chisholm и Chanadian (1976), Vermeulen и De Sy (1976), Hammond и соавторы (1978) выявлено значительное увеличение концентрации плазменного ДГТ у мужчин 50—80 лет с гиперплазией предстательной железы, чего не наблюдалось у здоровых мужчин этого возраста.
Случай лечения пожилого пациента с доброкачественной аденомой простаты

Пациент жаловался на чувство неполного опорожнения мочевого пузыря, вялую струю мочи и длинную паузу перед мочеиспусканием. Ему также приходилось вставать по 3-4 раза за ночь, чтобы сходить в туалет.
Анамнез
Пациент впервые обратил внимание на ухудшение мочеиспускания примерно в 50 лет. По этому поводу обращался к урологу. Врач установил диагноз «аденома простаты» и «хронический проста тит» и назначил Тамсулозин и Простамол.
Больной прошёл курс лечения, который принёс временный положительный эффект. Но в последний год он заметил, что проблемы с мочеиспусканием стали прогрессировать.
Регулярные осмотры у уролога и специального лечения не проходил. Оперативный анамнез по урологическому профилю не отягощён.
Обследование
- состояние удовлетворительное;
- при ощупывании живота и постукивании по пояснице боли нет;
- почки, мочевой пузырь и яички в норме;
- мошонка, придатки, семенные канатики и вены нормальных размеров и формы;
- крайняя плоть открывается свободно;
- предстательная железа безболезненная, эластичная, без очаговых уплотнений, но значительно увеличена;
- мочеиспускание тоже безболезненное, но затруднённое, крови нет;
- дизурия (боль при мочеиспускании) умеренная.
По результатам УЗИ простаты с определением остаточной мочи у пациента выявили признаки узловой гиперплазии, диффузные изменения, калькулёзный простатит и кисту простаты.
- объём предстательной железы — 118 куб. см;
- объём остаточной мочи — 80 мл;
- общий ПСА — 8,54 нг/мл.
- максимальная скорость (Qmax) — 9 мл/сек.;
- средняя скорость — 6 мл/сек.
Диагноз
ИБС с атеросклеротическим кардиосклерозом. Гипертония 3-й степени, риск осложнений — 4. Хроническая сердечная недостаточность 1-го класса.
Сахарный диабет 2-го типа, целевой уровень гликогемоглобина (HbA1c) менее 7,5 %. Диабетическая нефропатия и нефросклероз. Хроническая болезнь почек на стадии 3А.
Лечение
Пациенту назначили комбинированный препарат Дутастерид/Тамсулозин 0,5/0,4 мг один раз в сутки через полчаса после еды. От оперативного лечения (трансуретральной резекции простаты) решили воздержаться из-за возраста и сопутствующих патологий больного.
На фоне приёма препарата пациент отметил заметное улучшение мочеиспускания. Чтобы исключить нарастание остаточной мочи и ПСА, контрольные обследования проводятся ежегодно. По результатам диагностики 2021 года:
- объём простаты уменьшился до 90 куб. см;
- объём остаточной мочи снизился до 40 мл;
- общий ПСА сократился до 3,611 нг/мл;
- Qmax — 11 мл/сек;
- средняя скорость — 8 мл/сек.
Заключение
Данный клинический случай подтверждает, что приём комбинированного препарата Дутастерид/Тамсулозин является действенным методом для лечения пациентов с большой аденомой простаты (более 45 куб. см.). В описываемом случае терапия позволила избежать обострения хронической задержки мочеиспускания и снизила уровень общего ПСА.
Предыдущий клинический случай
Информация, представленная на сайте, не может быть использована для постановки диагноза, назначения лечения и не заменяет прием врача.
Аденома предстательной железы ( Аденома простаты )
Аденома предстательной железы – это разрастание железистой ткани простаты, ведущее к нарушению оттока мочи из мочевого пузыря. Характерно учащенное и затрудненное мочеиспускание, в т. ч. ночное, ослабление струи мочи, непроизвольное выделение мочи, давление в области мочевого пузыря. Впоследствии может развиться полная задержка мочи, воспаление мочевого пузыря и почек. Хроническая задержка мочи ведет к интоксикации, почечной недостаточности. Диагностика включает УЗИ простаты, исследование ее секрета, при необходимости - биопсию. Лечение, как правило, хирургическое. Консервативная терапия эффективна на ранних стадиях.
МКБ-10

Общие сведения
Аденома простаты – доброкачественное новообразование парауретральных желез, располагающихся вокруг уретры в ее простатическом отделе. Основной симптом аденомы предстательной железы - нарушение мочеиспускания вследствие постепенного сдавления уретры одним или несколькими растущими узелками. Для патологии характерно доброкачественное течение.
За медицинской помощью обращается лишь малая часть больных, однако, детальное обследование позволяет обнаружить симптомы заболевания у каждого четвертого мужчины в возрасте 40-50 лет и у половины мужчин от 50 до 60 лет. Болезнь выявляется у 65% мужчин в возрасте 60-70 лет, 80% мужчин в возрасте 70-80 лет и более 90% мужчин в возрасте старше 80 лет. Выраженность симптоматики может существенно различаться. Исследования в области клинической андрологии говорят о том, что проблемы при мочеиспускании возникают примерно у 40% мужчин с аденомой простаты, но только каждый пятый больной из этой группы обращается за медицинской помощью.
Причины
Механизм развития аденомы предстательной железы пока до конца не определен. Несмотря на распространенное мнение, связывающее патологию с хроническим простатитом, нет данных, которые подтвердили бы связь этих двух заболеваний. Исследователи не выявили никакой связи между развитием аденомы простаты и употреблением алкоголя и табака, сексуальной ориентацией, половой активностью, перенесенными венерическими и воспалительными заболеваниями.
Отмечается выраженная зависимость частоты возникновения аденомы предстательной железы от возраста больного. Ученые полагают, что аденома развивается вследствие нарушений гормонального фона у мужчин при наступлении андропаузы (мужского климакса). Данная теория подтверждается тем, что от патологии никогда не страдают мужчины, кастрированные до наступления половой зрелости и чрезвычайно редко – мужчины, кастрированные после ее наступления.
Симптомы аденомы простаты
Существует две группы симптомов заболевания: ирритативные и обструктивные. К первой группе симптомов относится учащение мочеиспускания, настойчивые (императивные) позывы на мочеиспускание, никтурия, недержание мочи. В группу обструктивных симптомов включают затруднения при мочеиспускании, задержку начала и увеличение времени мочеиспускания, чувство неполного опорожнения, мочеиспускание прерывистой вялой струей, необходимость натуживания. Выделяется три стадии аденомы простаты: компенсированная, субкомпенсированная и декомпенсированная.
Компенсированная стадия
На компенсированной стадии меняется динамика акта мочеиспускания. Оно становится более частым, менее интенсивным и менее свободным. Появляется необходимость 1-2 раза помочиться ночью. Как правило, никтурия на I стадии аденомы простаты не вызывает беспокойства у больного, который связывает постоянные ночные пробуждения с развитием возрастной инсомнии. Днем нормальная частота мочеиспускания может быть сохранена, однако пациенты с I стадией аденомы простаты отмечают период ожидания, особенно выраженный после ночного сна.
Затем частота дневных мочеиспусканий увеличивается, а объем мочи, выделяемой за однократное мочеиспускание, уменьшается. Возникают императивные позывы. Струя мочи, которая ранее образовывала параболическую кривую, выделяется вяло и падает практически вертикально. Развивается гипертрофия мышц мочевого пузыря, благодаря которой сохраняется эффективность его опорожнения. Остаточной мочи в мочевом пузыре на этой стадии нет или практически нет (менее 50 мл). Функциональное состояние почек и верхних мочевыводящих путей сохранено.
Субкомпенсированная стадия
На II стадии аденомы предстательной железы мочевой пузырь увеличивается в объеме, в его стенках развиваются дистрофические изменения. Количество остаточной мочи свыше 50 мл и продолжает увеличиваться. На всем протяжении акта мочеиспускания больной вынужден интенсивно напрягать мышцы брюшного пресса и диафрагмы, что приводит к еще большему повышению внутрипузырного давления.
Акт мочеиспускания становится многофазным, прерывистым, волнообразным. Постепенно нарушается пассаж мочи по верхним мочевыводящим путям. Мышечные структуры теряют эластичность, мочевые пути расширяются. Нарушается функция почек. Пациентов беспокоит жажда, полиурия и другие симптомы прогрессирующей хронической почечной недостаточности. При срыве механизмов компенсации наступает третья стадия.
Декомпенсированная стадия
Мочевой пузырь у больных с III стадией аденомы простаты растянут, переполнен мочой, легко определяется пальпаторно и визуально. Верхний край мочевого пузыря может доходить до уровня пупка и выше. Опорожнение невозможно даже при интенсивном напряжении мышц брюшного пресса. Желание опорожнить мочевой пузырь становится непрерывным. Возможны сильные боли внизу живота. Моча выделяется часто, каплями или очень малыми порциями. В дальнейшем боли и позывы к мочеиспусканию постепенно ослабевают.
Развивается характерная парадоксальная задержка мочи, или парадоксальная ишурия (мочевой пузырь переполнен, моча постоянно выделяется по каплям). Верхние мочевыводящие пути расширены, функции почечной паренхимы нарушены вследствие постоянной обструкции мочевых путей, приводящей к повышению давления в чашечно-лоханочной системе. Нарастает клиника хронической почечной недостаточности. Если медицинская помощь не оказывается, больные погибают от прогрессирующей ХПН.
Осложнения
Если лечебные мероприятия не проводятся, у больного с аденомой простаты возможно развитие хронической почечной недостаточности. Иногда возникает острая задержка мочи. Больной не может помочиться при переполненном мочевом пузыре, несмотря на интенсивное желание. Для устранения задержки мочи проводится катетеризация мочевого пузыря у мужчин, иногда – экстренная операция или пункция мочевого пузыря.
Еще одно осложнение аденомы простаты – гематурия. У ряда больных отмечается микрогематурия, но нередки и интенсивные кровотечения из ткани аденомы (при травме в результате манипуляции) или варикозное расширение вен в области шейки мочевого пузыря. При образовании сгустков возможно развитие тампонады мочевого пузыря, при которой необходима экстренная операция. Часто причиной кровотечения становится диагностическая или лечебная катетеризация.
Камни в мочевом пузыре могут появиться в результате застоя мочи или мигрировать из почек и мочевыводящих путей. При цистолитиазе клиническая картина аденомы дополняется учащением мочеиспускания и болями, иррадиирующими в головку полового члена. В положении стоя, при ходьбе и движениях симптоматика становится более выраженной, в положении лежа – уменьшается.
Характерен симптом «закладывания струи мочи» (несмотря на неполное опорожнение мочевого пузыря, струя мочи внезапно прерывается и возобновляется только при изменении положения тела). Нередко развиваются инфекционные заболевания (эпидидимоорхит, эпидидимит, везикулит, аденомит, простатит, уретрит, острый и хронический пиелонефрит).
Диагностика
Для того, чтобы оценить выраженность симптомов аденомы простаты, больному предлагают заполнить дневник мочеиспусканий. Во время консультации врач-уролог проводит пальцевое исследование простаты. Для исключения инфекционных осложнений производится забор и исследование секрета простаты и мазков из уретры. Дополнительное обследование включает:
- Эхографию. В процессе УЗИ простаты определяют объем предстательной железы, выявляют камни и участки с застойными явлениями, оценивают количество остаточной мочи, состояние почек и мочевыводящих путей.
- Исследование уродинамики. Достоверно судить о степени задержки мочи позволяет урофлоуметрия (время мочеиспускания и скорость потока мочи определяется специальным аппаратом).
- Определение онкомаркеров. Для исключения рака предстательной железы необходимо оценить уровень ПСА (простатоспецифического антигена) величина которого в норме не должна превышать 4нг/мл. В спорных случаях проводится биопсия простаты.
Цистография и экскреторная урография при аденоме простаты в последние годы проводятся реже в связи с появлением новых, менее инвазивных и более безопасных методов исследования (УЗИ). Иногда для исключения заболеваний со схожей симптоматикой или при подготовке к оперативному лечению выполняют цистоскопию.
Лечение аденомы простаты
Консервативная терапия
Консервативная терапия проводится на ранних стадиях и при наличии абсолютных противопоказаний к операции. Для уменьшения выраженности симптомов заболевания применяют альфа-адреноблокаторы (альфузозин, теразозин, доксазозин, тамсулозин), ингибиторы 5-альфа редуктазы (дутастерид, финастерид), препараты растительного происхождения (экстракт коры африканской сливы или плодов сабаля).
Для борьбы с инфекцией, часто присоединяющейся при аденоме простаты, назначают антибиотики (гентамицин, цефалоспорины). По окончании курса антибиотикотерапии применяют пробиотики, восстанавливающие нормальную микрофлору кишечника. Проводят коррекцию иммунитета (альфа-2b интерферон, пирогенал). Атеросклеротические изменения сосудов, развивающиеся у большинства пожилых больных, препятствуют поступлению лечебных препаратов в предстательную железу, поэтому для нормализации кровообращения назначают трентал.
Хирургическое лечение
Существуют следующие хирургические методики лечения аденомы простаты:
- ТУР (трансуретральная резекция). Малоинвазивная эндоскопическая методика. Операция проводится объеме аденомы менее 80 см3. Не применяется при почечной недостаточности.
- Аденомэктомия. Проводится при наличии осложнений, массе аденомы более 80 см3. В настоящее время широко применяется лапароскопическая аденомэктомия.
- Лазерная вапоризация простаты. Позволяет проводить операцию при массе опухоли менее 30-40 см3. Является методом выбора для молодых пациентов с аденомой простаты, поскольку позволяет сохранить половую функцию.
- Лазерная энуклеация (гольмиевая - HoLEP, тулиевая - ThuLEP). Метод признан "золотым стандартом" хирургического лечения аденомы простаты. Позволяет удалить аденому объемом свыше 80 см3 без открытого вмешательства.
Выделяют ряд абсолютных противопоказаний к оперативному лечению аденомы простаты (декомпенсированные заболевания дыхательной и сердечно-сосудистой системы и т. д.). Если хирургическое лечение невозможно, выполняется катетеризация мочевого пузыря или паллиативные оперативные вмешательства – цистостомия, установка уретрального стента.
1. Доброкачественная гиперплазия предстательной железы: учебно-методическое пособие/ Князюк А.С. – 2012.
2. Доброкачественная гиперплазия предстательной железы. Библиотека пациента. Урология/ Пушкарь Д.Ю. , Раснер П.И.// Русский медицинский журнал. – 2013 - №18.
3. Диагностика и лечение доброкачественной гиперплазии предстательной железы/ Аляев Ю.Г., Григорян В.А., Чиненов Д.В.// Лечащий врач. – 2007.
4. Расстройства мочеиспускания у мужчин: методические рекомендации/ Раснер П.И., Газимиев М.А., Гаджиева З.К., Касян Г.Р. – 2017.
Читайте также:
- Опухоли из клеток Сертоли и Лейдига - клиника, лечение
- Примеры периферической экссудативной геморрагической хориоретинопатии, симулирующей меланому хориоидеи
- Лучевая диагностика абсцесса жевательного пространства
- Показания для операции на позвоночнике при анкилозирующем спондилите (болезни Бехтерева)
- Лучевая диагностика пассивного полнокровия печени
